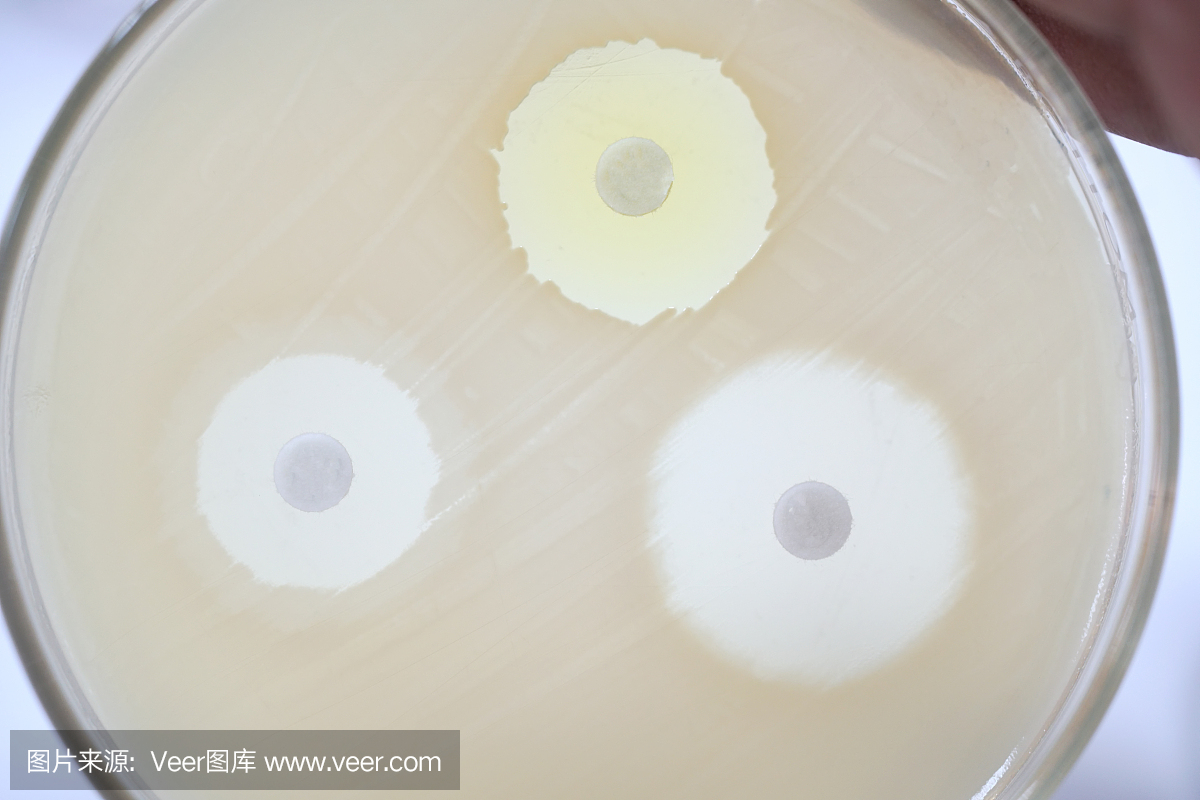
通过扩散测试的方式对细菌的抗生素敏感性是一

细菌抗生素敏感性试验。将含有不同抗生素的薄
1200x795 - 884KB - JPEG

细菌抗生素敏感性试验。将含有不同抗生素的薄
795x1200 - 1100KB - JPEG

模型发布。抗生素敏感性试验。研究人员测试了
1280x949 - 236KB - JPEG
使用抗生素应以细菌药敏实验结果为依据 细菌
388x220 - 11KB - JPEG

抗菌药物敏感性试验。微生物学家左和技术员进
1280x858 - 272KB - JPEG

通过扩散测试的方式对细菌的抗生素敏感性是一
1200x800 - 569KB - JPEG

抗生素敏感性试验
1161x1200 - 1479KB - JPEG

微生物学家拿着细菌的卡尺和抗生素敏感板
1200x801 - 603KB - JPEG

慢性化脓性中耳炎的细菌培养与抗菌素敏感试验
280x280 - 4KB - JPEG

微生物学家持有大肠杆菌细菌的抗生素敏感板
1200x801 - 573KB - JPEG

抗生素敏感性试验
1200x712 - 136KB - JPEG
通过扩散测试的方式对细菌的抗生素敏感性是一
1200x800 - 492KB - JPEG

抗生素耐药性大肠杆菌。在大肠杆菌中对抗生素
1280x894 - 168KB - JPEG

微生物学家持有铜绿假单胞菌细菌的抗生素敏感
1200x801 - 560KB - JPEG

微生物实验室抗生素敏感性检测
1200x803 - 444KB - JPEG
细菌对抗生素敏感试验有以下三种方式。1.扩散法 琼脂加上细菌所需要的各种养料,将培养基融化后,倒入无菌
而且还有肺脓肿,用抗生素类药已经有6个月了当细菌培养转为阴性后,为防止复发,上述用药还应持续1~2周。
培养后细菌就会分别在平皿上裂殖,如果在平皿的培养基内事先加入抗生素纸片,即为试验菌株的敏感度
好大夫问答知识库【细菌对抗生素敏感试验】页面汇总了和细菌对抗生素敏感试验内容相关的、患者在好大夫在线
细菌对抗生素敏感试验正常值 敏感记为(S)。中敏记为(I)。耐药记为(R)。细菌对抗生素敏感试验临床意义 反映
药物敏感试验简称药敏试验(或耐药试验)。旨在了解病原微生物对各种抗生素的敏感(或耐受)程度,以指导
细菌对抗生素敏感试验,青岛海博生物,快速显色微生物培养基生产,显色培养基,植物组织培养基制造,微生物知识,
细菌对抗生素的敏感试验,有什么.,细菌对抗生素的敏感试验,有什么临床意义?
细菌对抗生素敏感试验直接法与标准法比较,抗生素敏感试剂;直接法;标准法,贾淑芳,赵星,陈春燕,西南国防
养生之道网细菌对抗生素敏感试验专区,为您整合了包括细菌对抗生素敏感试验费用、多少钱,细菌对抗生素敏感